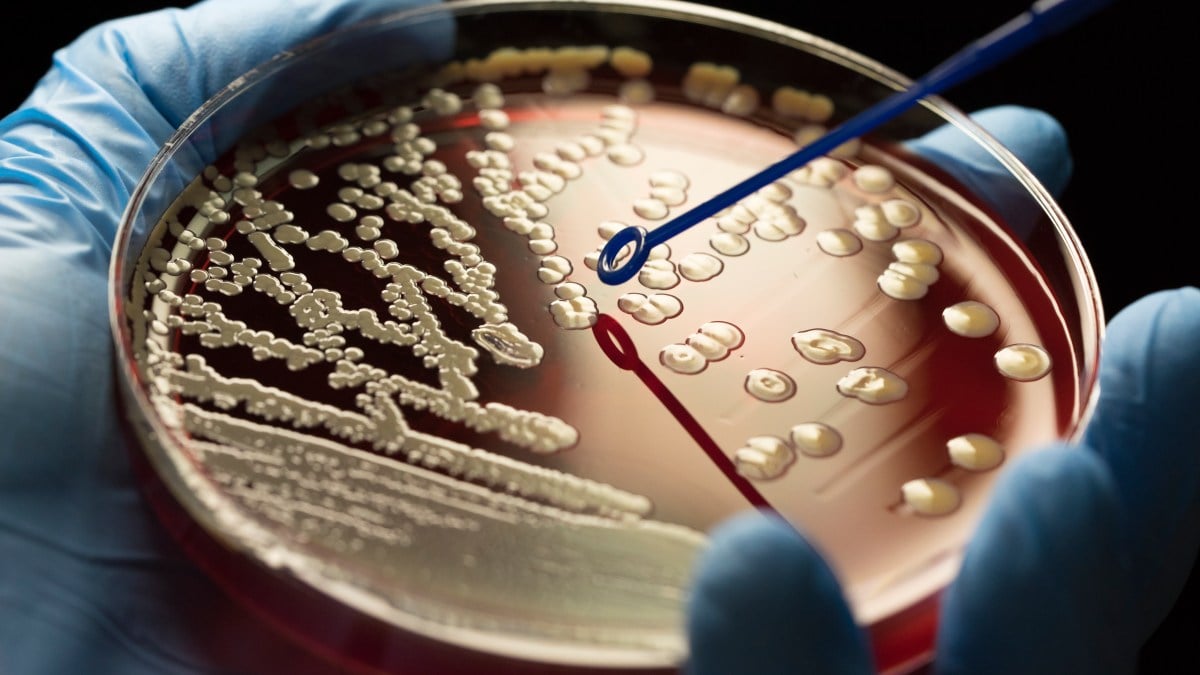
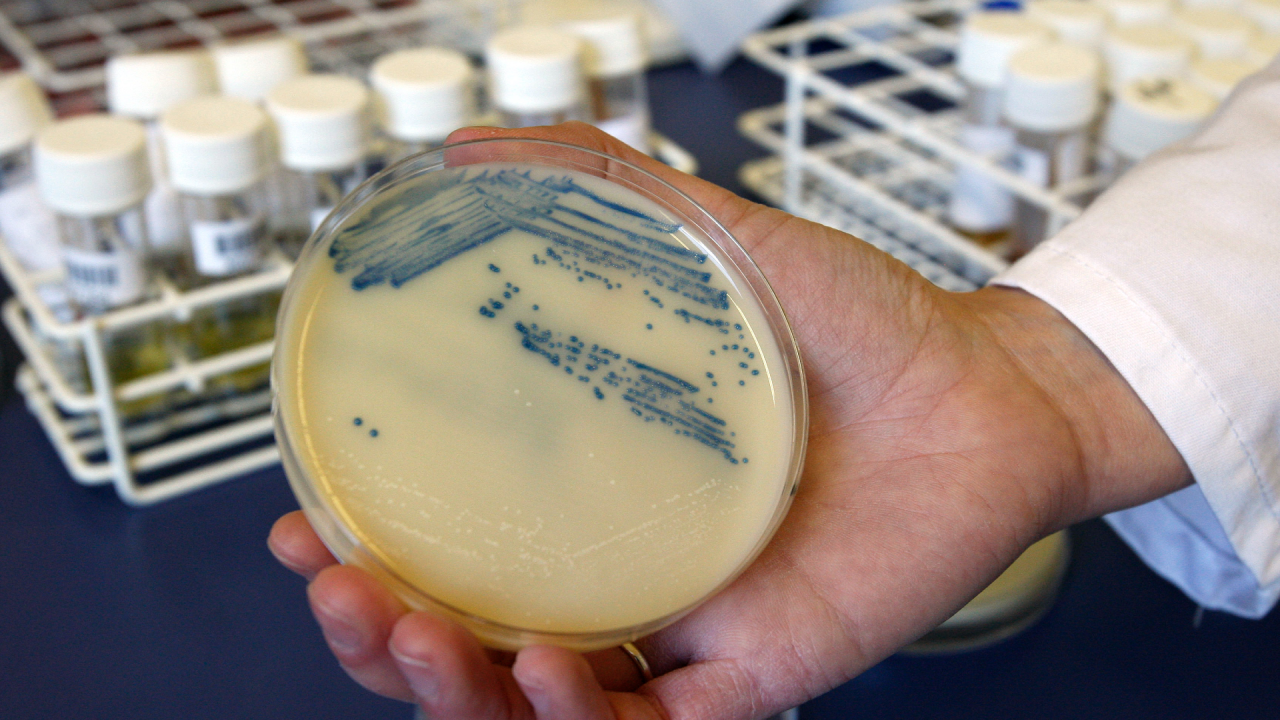

Hidden Antibiotic in Plain Sight Shows Promise Against Superbugs
Scientists discovered a new antibiotic compound, pre-methylenomycin C lactone, from soil bacteria that shows strong activity against drug-resistant bacteria like MRSA and E. faecium, without inducing resistance, offering promising potential for future antibiotic development.